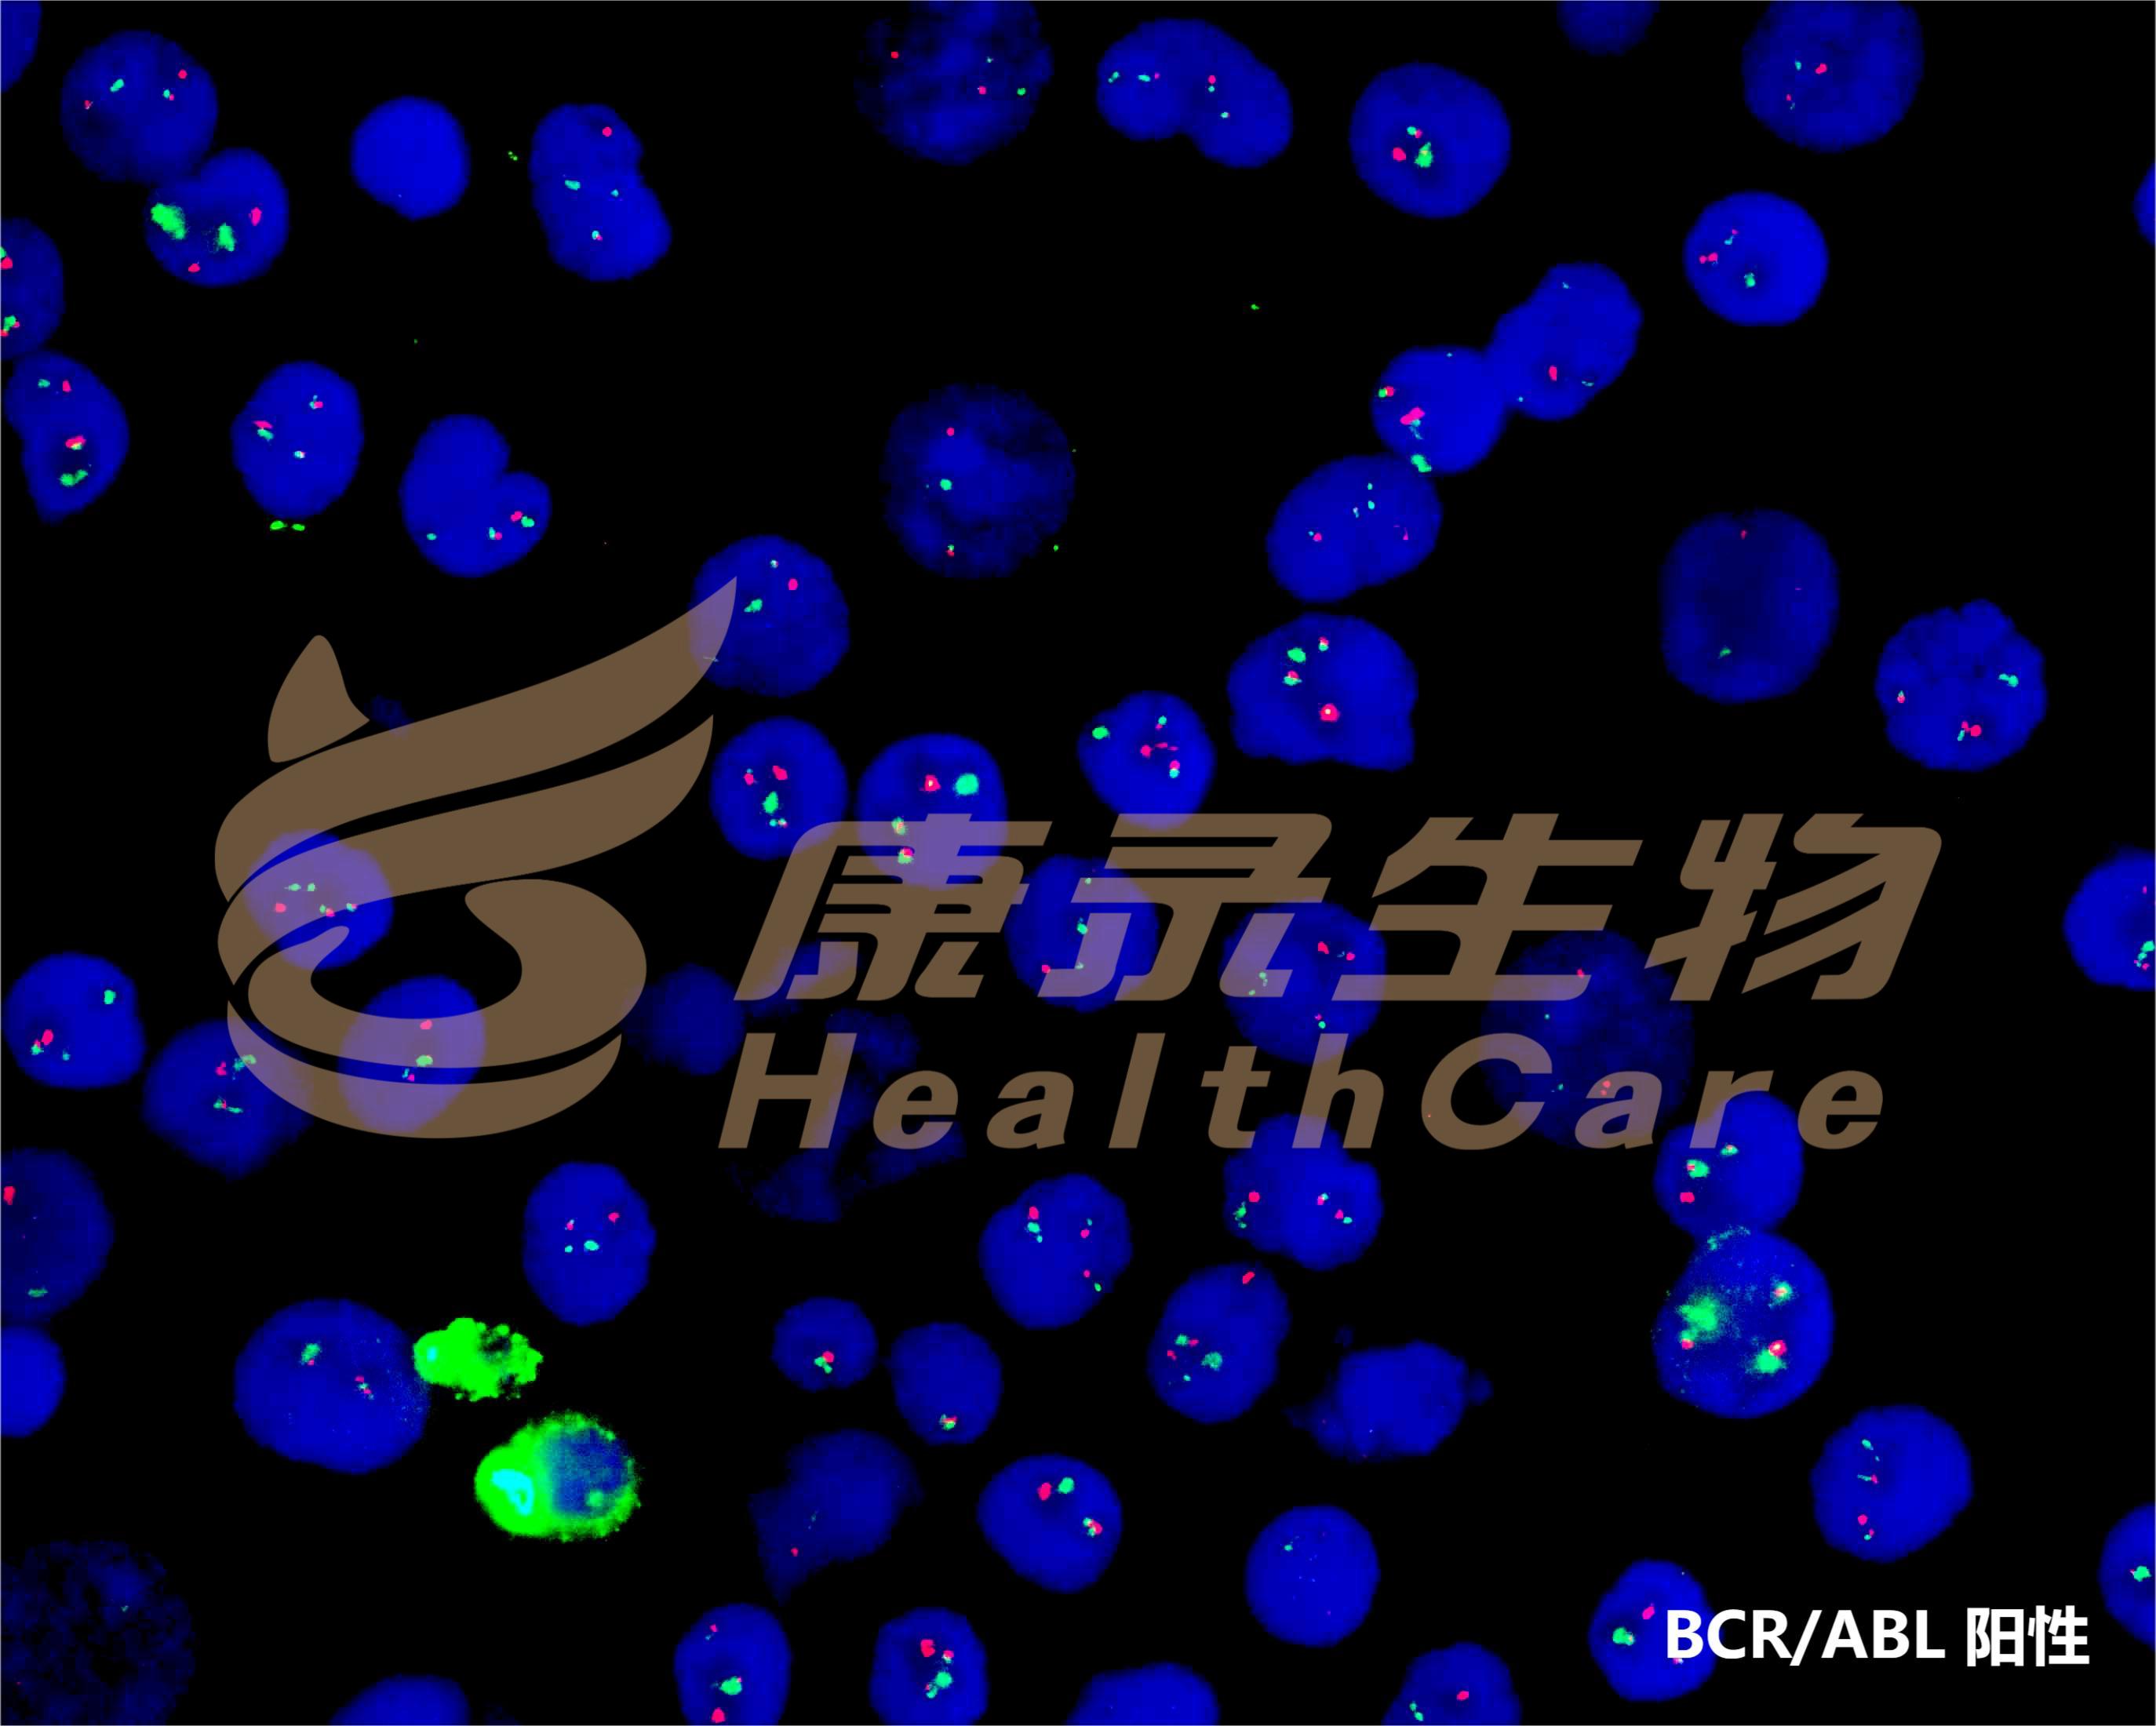

Product Center
产品中心


货号FP-003
BCR/ABL融合基因检测试剂盒(荧光原位杂交法)
探针设计
ABL基因(9q34.11-13)标记为橘红色,长度为600kb;
BCR基因(22q11.22-23)标记为绿色,总长度为1000kb。

临床意义
- 慢性粒细胞白血病CML
- 急性淋巴细胞白血病ALL
参考文献
Hehne S, et al. (2012) Pathol Res Pract 208: 510-7.
Lim TH, et al. (2005) Ann Acad Med Singapore 34: 533-8.
Zheng X, et al. (2009) PLoS One 4: e7661.
Exp Mol Pathol. 2006;81(1):1-7.
Blood. 2021 Apr 29;137(17):2418.
Ann Lab Med. 2018 Mar;38(2):169-171.
J Environ Pathol Toxicol Oncol. 2018;37(2):117-126.
Lim TH, et al. (2005) Ann Acad Med Singapore 34: 533-8.
Zheng X, et al. (2009) PLoS One 4: e7661.
Exp Mol Pathol. 2006;81(1):1-7.
Blood. 2021 Apr 29;137(17):2418.
Ann Lab Med. 2018 Mar;38(2):169-171.
J Environ Pathol Toxicol Oncol. 2018;37(2):117-126.